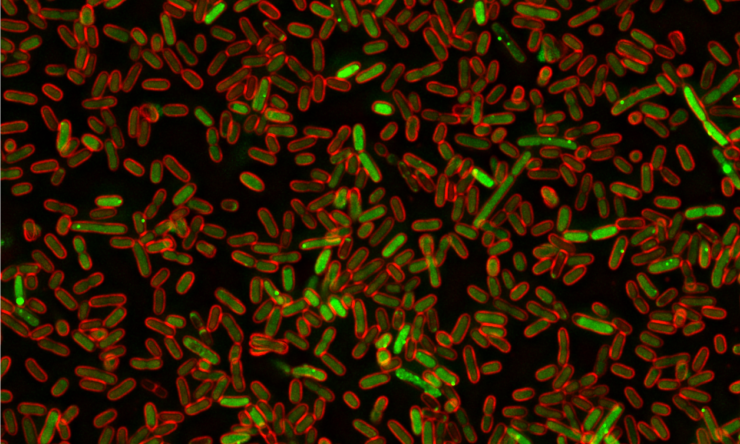
A team led by researchers at Baylor College of Medicine and the University of Texas at Austin has applied an unconventional approach that used bacteria to discover human proteins that can lead to DNA damage and promote cancer.

Bacteria help discover human cancer-causing proteins

A team led by researchers at Baylor College of Medicine and the University of Texas at Austin has applied an unconventional approach that used bacteria to discover human proteins that can lead to DNA damage and promote cancer. Reported in the journal Cell, the study also proposes biological mechanisms by which these proteins can cause damage to DNA, opening possibilities for future cancer treatments.
“Our cells make protein carcinogens,” said co-corresponding author Dr. Susan M. Rosenberg, Ben F. Love Chair in Cancer Research and professor of molecular and human genetics, of molecular virology and microbiology and of biochemistry and molecular biology at Baylor. “Cancer is a disease of mutations. A normal cell that has accumulated several mutations in particular genes becomes likely to turn into a cancer cell.”
Mutations that cause cancer can be the result of DNA damage. External factors such as tobacco smoke and sunlight can damage DNA, but most DNA damage seems to result from events that occur within cells and is mediated by cellular components, including proteins. Despite the importance of these events, they have not been studied extensively.
“One way proteins can cause DNA damage is by being overproduced, which is a relatively frequent cellular event,” said Rosenberg, who also is leader of the Cancer Evolvability Program at the Dan L Duncan Comprehensive Cancer Center at Baylor. “In this study, we set out to uncover proteins that, when overproduced by the cell, cause damage to DNA in ways that can lead to cancer.”
To uncover these DNA “damage-up” proteins, the researchers took an unconventional approach. They searched for proteins that promote DNA damage in human cells by looking at proteins that, when overproduced, would cause DNA damage in the bacterium E. coli.
“Although bacteria and people are different, their basic biological processes are similar, so with this approach we thought we might find common mechanisms of DNA damage that could be relevant to cancer,” Rosenberg said.
“This was a wild idea,” said Rosenberg, and was possible because of funding from two sources aimed at trying high-risk strategies that, if successful, would have high impact: a National Institutes of Health Director’s Pioneer Award and a gift from the W.M. Keck Foundation, among many other grants to the 16-lab team.
E. coli reveals novel candidates for cancer-promoting proteins
The researchers genetically modified bacteria so they would fluoresce red when DNA was damaged. Then, they overexpressed each of the 4,000 genes present in E coli individually and determined which ones made bacteria glow red.
“We uncovered an extensive and varied network of proteins that, when overproduced, alter cells in ways that lead to DNA damage,” Rosenberg said. “Some of these proteins are, as expected, involved in DNA processing or repair, but, surprisingly, most are not directly connected to DNA. For instance, some of the DNA damage-up proteins participate in the transport of molecules across the cell membrane.”
When the researchers looked for human protein relatives of the DNA “damage-up” proteins they had found in bacteria, they identified 284. Interestingly, they determined that these human proteins are linked to cancer more often than random sets of proteins. In addition, the proteins’ RNAs, an indicator of protein production, predicted mutagenesis in tumors and poor patient prognosis. When the researchers overproduced these proteins in human cells in the lab, half of the proteins triggered DNA damage and mutation.
“We showed that E. coli can help to identify DNA damage-up proteins and mechanisms of action in human cells quickly and inexpensively. Some of the proteins and their mechanisms were known to be involved in cancer, but many others were not suspected of being in the cancer-causing list,” said co-corresponding author Dr. Christophe Herman, professor of molecular and human genetics and molecular virology and microbiology at Baylor College of Medicine and member of the Dan L Duncan Comprehensive Cancer Center.
“I think it is extraordinary to identify so many ways DNA can be damaged. This study is opening up new avenues for discoveries of novel mechanisms that protect our genomes and how their dysfunction can alter the integrity of our DNA and cause cancer,” said co-corresponding author Dr. Kyle M. Miller, associate professor of molecular biosciences at the University of Texas at Austin and member of the Dan L Duncan Comprehensive Cancer Center at Baylor. “It is yet another example of the power of model organisms to uncover basic biological processes that can shine a light on how human cells and cancer work.”
“Our work has significant implications both in basic biological fields and in clinical research,” Rosenberg said. “We provide a previously unknown understanding of the diverse mechanisms that can generate DNA damage leading to cancer. In the future, this finding may lead to new ways to identify people who are likely to develop cancer so that strategies to prevent it, slow it down or catch it early can be used.”
The study’s two co-first authors were students earning their doctorates: Dr. Jun Xia at Baylor College of Medicine and Dr. Liya Chiu at the University of Texas at Austin.
See a complete list of all the contributors and their affiliations and the financial support of this study.